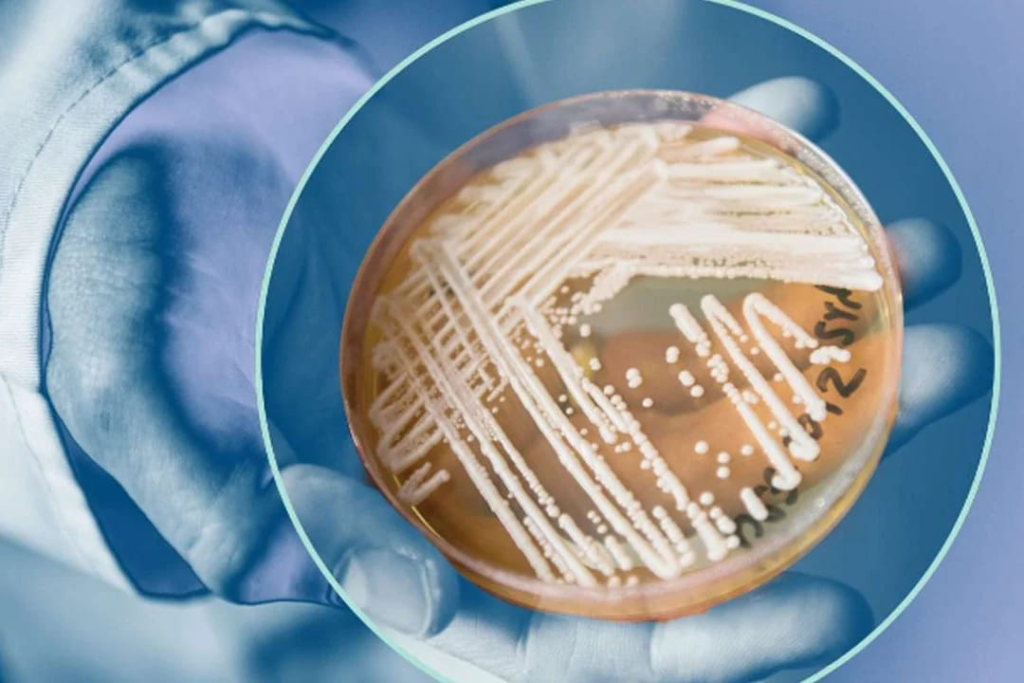
Fungus

Date: 4/2/2024
అమెరికాలో వేగంగా వ్యాపిస్తోన్న ప్రాణాంతక ఫంగల్ ఇన్ఫెక్షన్ ‘కాండిడా ఆరిస్’
అమెరికాలో వేగంగా వ్యాపిస్తోన్న ప్రాణాంతక ఫంగల్ ఇన్ఫెక్షన్ ‘కాండిడా ఆరిస్’
ఈ నెలలో వాషింగ్టన్లో నలుగురికి పాజిటివ్గా నిర్ధారణ
మరణాల రేటు అధికంగా ఉందని హెచ్చరిస్తున్న వైద్య నిపుణులు
15 ఏళ్లక్రితం జపాన్లో తొలిసారి కేసుల గుర్తింపు.. క్రమంగా పెరుగుతున్న కేసులు
షర్మిలను పై సోషల్ మీడియాలో అవమానించడంపై రాహుల్ గాంధీ స్పందన..

మహిళలను అవమానించడం, వారిపై దాడి చేయడం పిరికి పందల చర్య. దురదృష్టవశాత్తూ ఇటీవల కాలంలో ఇది శక్తిహీనులకు ఒక ఆయుధంగా మారిపోయింది. వైఎస్ షర్మిల, వైఎస్ సునీతపై జరిగిన ఈ అవమానకరమైన దాడిని నేనూ, కాంగ్రెస్ పార్టీ నిర్ద్వందంగా ఖండిస్తున్నాం అంటూ రాహుల్ ట్వీట్ లో పేర్కొన్నారు.
తెలంగాణ: భువనగిరి ఎస్సీ హాస్టల్ లో ఇద్దరు విద్యార్థినుల ఆత్మహత్య

తెలంగాణ: భువనగిరి ఎస్సీ హాస్టల్ లో ఇద్దరు విద్యార్థినుల ఆత్మహత్య
ఒకే గదిలో రెండు ఫ్యాన్లకు ఉరేసుకున్న బాలికలు
ఏ తప్పు చేయకున్నా మమ్మల్ని నిందిస్తున్నారంటూ సూసైడ్ నోట్
విద్యార్థినుల మృతదేహాలతో తల్లిదండ్రుల ఆందోళన
Date: 3/2/2024
సజ్జలకు ఏ ప్రాతిపదికన క్యాబినెట్ హోదా కల్పించారు?: నాదెండ్ల

సజ్జలకు ఏ ప్రాతిపదికన క్యాబినెట్ హోదా కల్పించారు?: నాదెండ్ల
ప్రభుత్వ సలహాదారుల విషయమై విమర్శల దాడిని కొనసాగించిన నాదెండ్ల
సజ్జల రూ.2.40 లక్షల వేతనం తీసుకుంటున్నారని వెల్లడి
సీఎంకు ఉపన్యాసాలు రాయడమే సలహాదారు పని అని వ్యాఖ్యలు
ప్రధానమంత్రిని వాడు, వీడు అని అనడం షర్మిల రాజకీయ దివాలాకోరుతనం: విష్ణువర్ధన్ రెడ్డి

ప్రధానమంత్రిని వాడు, వీడు అని అనడం షర్మిల రాజకీయ దివాలాకోరుతనం: విష్ణువర్ధన్ రెడ్డి
ఏపీకి ప్రత్యేక హోదా కోసం నిన్న ఢిల్లీలో షర్మిల ధర్నా
మాటల మధ్యలో మోదీ గాడు అంటూ పొరపాటున వ్యాఖ్యానించిన వైనం
ఇలాంటి మహిళ పీసీసీ అధ్యక్షురాలా? అంటూ విష్ణువర్ధన్ రెడ్డి ధ్వజం
భారత్ లోనూ హైస్పీడ్ రైళ్లు… శంషాబాద్ నుంచి నాలుగున్నర గంటల్లో విశాఖ!

భారత్ లోనూ హైస్పీడ్ రైళ్లు… శంషాబాద్ నుంచి నాలుగున్నర గంటల్లో విశాఖ!
ఇప్పటికే భారత్ లో వందే భారత్ రైళ్లు
వందే భారత్ రైళ్ల వేగం గంటకు 160 కి.మీ
గంటకు 220 కి.మీ వేగంతో ప్రయాణించనున్న హైస్పీడ్ రైళ్లు
హైదరాబాద్-విశాఖ… కర్నూలు-విజయవాడ రూట్లలో ప్రతిపాదనలు
Date: 2/2/2024
నన్ను చంపుతామని బెదిరిస్తున్నారు: పోలీసులకు ఫిర్యాదు చేసిన వైఎస్ సునీత

నన్ను చంపుతామని బెదిరిస్తున్నారు: పోలీసులకు ఫిర్యాదు చేసిన వైఎస్ సునీత
సోషల్ మీడియా వేదికగా బెదిరిస్తున్నారన్న సునీత
హైదరాబాద్ సైబర్ క్రైమ్ పోలీసులకు ఫిర్యాదు
చట్ట పరమైన చర్యలు తీసుకోవాలని విన్నపం
హైదరాబాద్ లో ఏపీ పోలీసుల గంజాయి దందా

హైదరాబాద్ లో ఏపీ పోలీసుల గంజాయి దందా
డ్యూటీకి సెలవు పెట్టి కారులో గంజాయి తరలిస్తున్న వైనం
శుక్రవారం తెల్లవారుజామున తనిఖీల్లో పట్టుబడ్డ ఇద్దరు కానిస్టేబుళ్లు
కారులో 22 కిలోల గంజాయి స్వాధీనం చేసుకున్న బాలానగర్ పోలీసులు
ఢిల్లీలో ఈ మధ్యాహ్నం దీక్షకు దిగుతున్న షర్మిల

ఢిల్లీలో ఈ మధ్యాహ్నం దీక్షకు దిగుతున్న షర్మిల.. శరద్ పవార్ తో భేటీ
ప్రత్యేక హోదాను ప్రధాన అస్త్రంగా మలుచుకుంటున్న షర్మిల
ఈ మధ్యాహ్నం ఏపీ భవన్ వద్ద దీక్ష
శరద్ పవార్ ను కలిసి మద్దతు కోరిన ఏపీసీసీ అధ్యక్షురాలు
ముంబైలో హైఅలర్ట్!

వరుస బాంబు పేలుళ్ల బెదిరింపులు.. ముంబైలో హైఅలర్ట్!
పలు ప్రాంతాల్లో పేలుళ్లు జరుగుతాయంటూ శుక్రవారం పోలీసులకు సందేశాలు
అప్రమత్తమైన పోలీసులు, పలు చోట్ల తనిఖీలు
బెదిరింపుల వెనక ఎవరున్నారో తేల్చేందుకు దర్యాప్తు ప్రారంభం
వీధి కుక్కల దాడిలో బాలుడు మృతి

శంషాబాద్ లో ఘోరం.. వీధి కుక్కల దాడిలో బాలుడు మృతి
ప్రసవం కోసం ఆసుపత్రిలో చేరిన తల్లి
అమ్మ కోసం ఏడుస్తూ గుడిసె బయటకొచ్చిన బాలుడు
కుక్కలు దాడి చేయడంతో తీవ్ర గాయాలు
Date: 1/2/2024
బడ్జెట్ లో ఏ శాఖకు ఎంతిచ్చారంటే..

రూ.7 లక్షల వరకు ఆదాయ పన్ను మినహాయింపు.. స్టాండర్డ్ డిడక్షన్ పెంపు
ఉద్యోగులకు స్టాండర్డ్ డిడక్షన్ రూ.75 వేలకు పెంపు
పన్ను శ్లాబులు యథాతథంగా కొనసాగుతాయని ప్రకటన
కార్పొరేట్ ట్యాక్స్ రేటు 22 శాతానికి తగ్గించిన కేంద్ర మంత్రి
రక్షణ శాఖకు పెద్దపీట.. రూ.6.2 లక్షల కోట్ల కేటాయింపు
గ్రామీణాభివృద్ధికి రూ.1.77 లక్షల కోట్లు
రైల్వేకు రూ.2.55 లక్షల కోట్లు ప్రకటించిన కేంద్ర మంత్రి
ఉపరితల రవాణా, జాతీయ రహదారులకు రూ. 2.78
రైల్వే శాఖకు రూ. 2.55
ప్రజా పంపిణీ శాఖకు రూ.2.13
హోం శాఖకు రూ. 2.03
గ్రామీణాభివృద్ది శాఖకు రూ.1.77
రసాయనాలు, ఎరువులకు రూ.1.68
కమ్యూనికేషన్ రూ.1.37
వ్యవసాయం, రైతు సంక్షేమానికి రూ.1.27
లోక్ సభలో మధ్యంతర బడ్జెట్ ప్రవేశపెట్టిన నిర్మలా సీతారామన్

“మళ్లీ గెలుస్తామని ఆశిస్తున్నాం”
80కోట్ల మందికి ఉచిత రేషన్ బియ్యం ద్వారా ఆహార సమస్యను పరిష్కరించాం.
అవినీతి నిరోధించాం.. పాలనలో పారదర్శక విధానాలను పాటిస్తున్నాం.
25కోట్ల మందిని పేదరికం నుంచి బయటకు తీసుకొచ్చాం.
34లక్షల కోట్ల రూపాయలను నేరుగా నగదు బదలీ ద్వారా పేదలకు అందించాం.
11.8 కోట్ల మంది రైతులకు నేరుగా నగదు సాయం అందిస్తున్నాం.
సామాజిక న్యాయం మా ప్రభుత్వం అనుసరించే విధానం.
నూతన సంస్కరణలతో కొత్త పారిశ్రామికవేత్తలు పుట్టుకొచ్చారు.
పదేళ్లలో ఆర్థిక వ్యవస్థ పురోగతికి చేరుకుంది.
సబ్ కా సాథ్.. సబ్కా వికాస్ మా నినాదం.
2047 నాటికి అభివృద్ధి చెందిన భారత్ గా అవతరించేందుకు కృషి చేస్తున్నాం.
అన్నదాతలకు కనీస మద్దతు ధరను దశలవారిగా పెంచాం.
నాణ్యమైన విద్య అందిస్తున్నాం.
పదేళ్లలో ఉన్నత విద్య చదివే అమ్మాయిల సంఖ్య 28శాతం పెరిగింది.
గత పదేళ్లలో 7 ఐఐటీ, 7ఐఐఎం, 16 ట్రిపుల్ ఐటీలు, 390 యూనివర్శిటీలు, 15 ఎయిమ్స్ లు ఏర్పాటు.
యువత అభివృద్ధికి ఎన్నో చర్యలు తీసుకున్నాం.
స్కిల్ ఇండియా మిషన్ తో 1.40కోట్ల మంది యువతకు నైపుణ్య శిక్షణ అందించాం
2023లో చెస్ లో 80మంది గ్రాండ్ మాస్టర్లు తయారయ్యారు.
ఔత్సాహిక మహిళా పారిశ్రామిక వేత్తలకు 30వేల కోట్లు ముద్రా రుణాలు.
పీఎం ఆవాస్ యోజన కింద ఇచ్చిన ఇళ్లలో 70శాతం మహిళలకే.
హైకమాండ్ తో నేను మాత్రమే ఎందుకు ఘర్షణ పడాలి?: బాలినేని శ్రీనివాసరెడ్డి

మాగుంటకు ఒంగోలు ఎంపీ టికెట్ ఇవ్వాలని పట్టుబడుతున్న బాలినేని
జిల్లాలోని ఎమ్మెల్యేలు, సమన్వయకర్తలు ఈ విషయంలో పట్టీపట్టనట్టు ఉన్నారని విమర్శ
ఎంపీగా ఎవరిని ప్రకటించినా అభ్యంతరం లేదని వ్యాఖ్య
నేడు మధ్యంతర బడ్జెట్ ప్రవేశపెట్టనున్న నిర్మలా సీతారామన్

అరుదైన ఘనత సొంతం!
ఇప్పటి వరకు వరుసగా ఐదుసార్లు బడ్జెట్ ప్రవేశపెట్టిన నిర్మలమ్మ
నేడు ప్రవేశపెట్టనున్న మధ్యంతర బడ్జెట్ ఆరోది
ఎన్నికల తర్వాత పూర్తిస్థాయి బడ్జెట్ను ప్రవేశపెట్టనున్న కొత్త ప్రభుత్వం
తాజా బడ్జెట్లో మహిళలు, రైతులను ఆకర్షించే ప్రకటనలు ఉండే అవకాశం
Date: 31/1/2024
యాదగిరి గుట్ట దేవస్థానంలో పనిచేసే ఉద్యోగులు, సచివాలయంలో మంత్రి శ్రీమతి కొండా సురేఖను కలిశారు

యాదగిరి గుట్ట శ్రీ లక్ష్మీ నరసింహ స్వామి దేవస్థానంలో పనిచేసే పలువురు మినిస్ట్రియల్, అర్చక, నాల్గవ తరగతి ఉద్యోగులు బుధవారం సచివాలయంలో దేవాదాయ ధర్మాదాయ శాఖ మంత్రి శ్రీమతి కొండా సురేఖ గారిని మర్యాదపూర్వకంగా కలిశారు. ఈ సందర్భంగా స్వామివారి చిత్రపటం, శేష వస్త్రాలు, ప్రసాదాలను మంత్రి గారికి అందించారు. దేవస్థానంలో చేపడుతున్న అభివృద్ధి కార్యక్రమాలు, భక్తులు సౌకర్యవంతంగా స్వామివారిని దర్శించుకునేందుకు చేపడుతున్న చర్యలను మంత్రి అడిగి తెలుసుకున్నారు.
తెలంగాణా రాష్ట్ర అకౌంటెంట్ జనరల్ (ఆడిట్ ) గా మాధవి
హైదరాబాద్, జనవరి 31 : తెలంగాణా రాష్ట్ర అకౌంటెంట్ జనరల్ (ఆడిట్ ) గా పీ. మాధవి నేడు భాద్యతలు స్వీకరించారు. 2001 ఇండియన్ ఆడిట్, అకౌంట్ సర్వీస్ బ్యాచ్ కు చెందిన మాధవి ప్రస్తుతం కంప్ట్రోలర్ ఆడిట్ జనరల్ స్థాయి హోదాలో ఉన్నారు.
గతంలో మహారాష్ట్ర ఏ.జీ. గా, చెన్నై రీజినల్ ట్రైనింగ్ ఇనిస్టిట్యూట్ ప్రిన్సిపాల్ డైరెక్టరుగా, ఆడిట్ ప్రిన్సిపాల్ డైరెక్టరుగా గతంలో పనిచేశారు. కొలంబో,పోర్ట్ లూయీస్, ప్రపంచ ఆరోగ్య సంస్థ , యునిసెఫ్, న్యూ యార్క్ లోని UNMEER లోనూ ఆడిట్ లను నిర్వహించారు. పీ. మాధవి నేడు తెలంగాణా రాష్ట్ర అకౌంటెంట్ జనరల్ (ఆడిట్ ) గా భాద్యత్రలు స్వీకరించిన సందర్బాగా ఆమెను పలువురు మర్యాదపూర్వకంగా అభినందించారు.
నిజం గెలవాలి

నిజం గెలవాలి, దర్శి నియోజకవర్గం టీడీపీ కార్యకర్త కుటుంబానికి నారా భువనేశ్వరి పరామర్శ.
దర్శి నియోజకవర్గం, దర్శి 5వ వార్డులో భువనేశ్వరి పర్యటన.
చంద్రబాబు అక్రమ అరెస్టును తట్టుకోలేక గుండెపోటుతో మృతిచెందిన కార్యకర్త తురిమెళ్ల పరిశుద్ధరావు(45).
పరిశుద్ధరావు చిత్రపటానికి భువనేశ్వరి నివాళులు.
భువనేశ్వరిని చూసి కన్నీటి పర్యంతం అయిన పరిశుద్ధరావు కుటుంబ సభ్యులు.
పరిశుద్ధరావు కుటుంబాన్ని ఓదార్చి, ధైర్యం చెప్పిన భువనేశ్వరి.
రూ.3లక్షల చెక్కు ఇచ్చి ఆర్ధికసాయం చేసిన భువనేశ్వరి.
రేపు శ్రీశైలం మల్లన్నను దర్శించనున్న లోకేష్
అమరావతి: తెలుగుదేశం పార్టీ జాతీయ ప్రధాన కార్యదర్శి నారా లోకేష్ గురువారం ప్రముఖ శైవక్షేత్రం శ్రీశైలం దేవస్థానాన్ని సందర్శించనున్నారు. ఉదయం 7.30 గంటలకు హైదరాబాద్ లోని నివాసం నుంచి లోకేష్ బయలుదేరనున్న లోకేష్ 9గంటలకు శ్రీశైలం మండలం సున్నిపెంట చేరుకుంటారు. అక్కడనుంచి బయలుదేరి 9.30గంటలకు సాక్షిగణపతి ఆలయాన్ని సందర్శిస్తారు. 9.40కి శ్రీశైలం ఆలయానికి చేరుకుంటారు. అక్కడ శ్రీభ్రమరాంబికా మల్లికార్జునస్వామిని దర్శించుకొని స్వామివారి పూజల్లో పాల్గొంటారు. 10.30కి అక్కడనుంచి బయలుదేరి సున్నిపెంట చేరుకొని, అనంతరం హైదరాబాద్ బయలుదేరి వెళతారు
గుంటూరు కొత్తపేట లో లలిత సూపర్ స్పెషాలిటీ హాస్పటల్ లో పెద్ద ఎత్తున IT సోదాలు..
ఢిల్లీ నుంచి వచ్చిన సెంట్రల్ సిబ్బంది సోదాలు నిర్వహిస్తున్నట్టు తెలుస్తుంది..
సుమారు 30 మంది సిబ్బందితో నాలుగు బ్రాంచ్ లో సోదాలు.
హాస్పటల్ లో రోగులను కుడా వెళ్లానివని వైనం..
రోగులకు కూడా పర్మిషన్ ఉంటే నే లోపలికి రండి అంటున్న IT కోరు అధికారులు.
హాస్పిటల్ లోకి మీడియాని అనుమతించని సిబ్బంది..
లోపల ఏం జరుగుతుందో బయటికి తెలియకుండా హాస్పిటల్ మేనేజ్ చేస్తున్నా సిబ్బంది ..
Budget Sessions 2024: బడ్జెట్ సమావేశాల్లో రాష్ట్రపతి ప్రసంగం!

జీవితంలో తొలిసారి పేదరిక నిర్మూలన చూస్తున్నా.. బడ్జెట్ సమావేశాల్లో రాష్ట్రపతి ప్రసంగం
పార్లమెంటు నూతన భవనంలో ప్రారంభమైన బడ్జెట్ సమావేశాల
ఉభయ సభలను ఉద్దేశించి రాష్ట్రపతి ముర్ము ప్రసంగం
తెలంగాణలో సమ్మక్క-సారక్క గిరిజన యూనివర్సిటీ ప్రారంభం కాబోతోందన్న రాష్ట్రపతి
గత పదేళ్లలో 25 కోట్ల మంది భారతీయులు పేదరికం నుంచి బయటపడ్డారన్న ముర్ము
190 అడుగుల ఎత్తుతో మోదీ విగ్రహం.. రూ. 200 కోట్లతో నిర్మించనున్న అస్సామీ వ్యాపారవేత్త

190 అడుగుల ఎత్తుతో మోదీ విగ్రహం.. రూ. 200 కోట్లతో నిర్మించనున్న అస్సామీ వ్యాపారవేత్త
పీఠం ఎత్తు 60 అడుగులతో కలిపి మొత్తంగా 250 అడుగుల మోదీ విగ్రహం
సొంత స్థలంలో నిర్మించనున్న వ్యాపారవేత్త నబీన్ చంద్రబోరా
పూర్తి వివరాలను పీఎంవోకు పంపిన నబీన్
గ్రీన్ సిగ్నల్ రావడంతో సోమవారం ప్రారంభమైన భూమిపూజ
విగ్రహాన్ని మోదీ చేతుల మీదుగా ఆవిష్కరించే యోచన
ప్రపంచంలోని అత్యంత అవినీతి దేశాలు ఇవే.. భారత్ స్థానంలో మార్పు లేదు!

ప్రపంచంలోని అత్యంత అవినీతి దేశాలు ఇవే.. భారత్ స్థానంలో మార్పు లేదు!
అవినీతి రహిత దేశంగా డెన్మార్క్
వరుసగా ఆరో ఏడాది కూడా టాప్ ప్లేస్లోనే
అత్యంత అవినీతి కలిగిన దేశాల్లో సోమాలియా టాప్
ఆ జాబితాలో భారత్ స్కోరు 39 మాత్రమే
2023 కరెప్షన్ ఇండెక్స్ను విడుదల చేసిన ట్రాన్స్పరెన్సీ ఇంటర్నేషనల్
నేడు ఏపీ కేబినెట్ సమావేశం.. మహిళలకు ఉచిత బస్సు ప్రయాణంపై నిర్ణయం

నేడు ఏపీ కేబినెట్ సమావేశం.. మహిళలకు ఉచిత బస్సు ప్రయాణంపై నిర్ణయం
పలు కీలక విషయాలను చర్చించనున్నకేబినెట్
ఉచిత బస్సు ప్రయాణంతో ప్రభుత్వంపై ఏటా రూ.1,440 కోట్ల భారం
డీఎస్సీ నోటిఫికేషన్ జారీపైనా చర్చ
ఎన్నికలే లక్ష్యంగా ప్రజలకు తాయిలాలు ప్రకటించే అవకాశం
Date: 30/1/2024

ఛత్తీస్ గఢ్ లో మావోల కాల్పులు… ముగ్గురు జవాన్ల మృతి
సుక్మా జిల్లా టేకులగూడ ఎదురుకాల్పులు
పెట్రోలింగ్ విధుల్లో ఉన్న జవాన్లపై మావోలు కాల్పులు
వెంటనే స్పందించి కాల్పులు జరిపిన జవాన్లు
అటవీప్రాంతంలోకి తప్పించుకున్న మావోలు

యూపీ నుంచి రాజ్యసభకు చిరంజీవి…?
ఇటీవల చిరంజీవికి పద్మ విభూషణ్
త్వరలో 15 రాష్ట్రాల్లో రాజ్యసభ ఎన్నికలు
ఒక్క యూపీలోనే 10 రాజ్యసభ స్థానాలు ఖాళీ
చిరంజీవిని యూపీ కోటాలో పెద్దల సభకు పంపేలా బీజేపీ ప్లాన్…?
మీడియాలో ఈ మేరకు కథనాలు

రేపటి నుండి పార్లమెంటు బడ్జెట్ సమావేశాలు… విపక్ష ఎంపీలపై సస్పెన్షన్ ఎత్తివేత
గత శీతాకాల సమావేశాల్లో పార్లమెంటులో భద్రతా వైఫల్యం
అనూహ్యరీతిలో చొరబడిన వ్యక్తులు
ఉభయ సభల్లో తీవ్ర ఆందోళన వ్యక్తం చేసిన ఎంపీలు
14 మంది ఎంపీలపై నాడు సస్పెన్షన్ వేటు
నేడు లోక్ సభ స్పీకర్, రాజ్యసభ చైర్మన్ తో మాట్లాడిన కేంద్రమంత్రి జోషి

గాంధీ వర్థంతిని అమరవీరుల సంస్మరణ దినంగా పాటిస్తున్నాం – దేశం కోసం మహోన్నత త్యాగాలు చేసిన వారిని స్మరించుకుందాం – నాడు జాతిపిత అనుసరించిన బాటలోనే నేడు పోరాటం చేయాలి – రాష్ట్రంలో విధ్వంస పాలనకు ముగింపు పలకాలి – మంచికి మద్దతు పలుకుతూ రామరాజ్య స్థాపనకు కృషి చేయాలి – మంచికి మద్దతు పలకడమే జాతిపితకు మనమిచ్చే అసలైన నివాళి :
టీడీపీ అధినేత చంద్రబాబు

జాతిపిత మహాత్మాగాంధీ వర్ధంతి సందర్భంగా సీఎం క్యాంప్ కార్యాలయంలో ఆయన చిత్రపటానికి నివాళులర్పించిన సీఎం వైఎస్ జగన్
ఈ కార్యక్రమంలో పాల్గొన్న పరిశ్రమలు, ఐటీ శాఖా మంత్రి గుడివాడ అమర్నాథ్, వైఎస్ఆర్సీపీ జాతీయ ప్రధాన కార్యదర్శి వి. విజయసాయి రెడ్డి, వైఎస్ఆర్సీపీ ఉత్తరాంధ్ర రీజనల్ కోఆర్డినేటర్ వైవీ. సుబ్బారెడ్డి

ప్రాణప్రతిష్ఠ కార్యక్రమానికి వెళ్లిన ఇమామ్కు ఫత్వా
తనకు వ్యక్తిగతంగా కొందరు ఫత్వా ఇచ్చారన్న ఆల్ ఇండియా ఇమామ్ ఆర్గనైజేషన్ చీప్
తనను బాయ్కాట్ చేయాలంటూ సోషల్ మీడియాలో ఇతర ఇమామ్లను కోరినట్టు వెల్లడి
దేశప్రజలందరూ ఒక్కటిగా ఉండాలని పిలుపు
Date: 29/1/2024

సుప్రీంకోర్టులో ఏపీ ప్రభుత్వానికి ఎదురుదెబ్బ.. చంద్రబాబు బెయిల్ తిరస్కరించాలన్న పిటిషన్ కొట్టివేత
ఇన్నర్ రింగ్ రోడ్డు కేసులో చంద్రబాబుకు ముందస్తు బెయిల్ ఇచ్చిన హైకోర్టు
హైకోర్టు ఉత్తర్వులను సుప్రీంకోర్టులో సవాల్ చేసిన ఏపీ ప్రభుత్వం
చంద్రబాబుకు నోటీసులు ఇచ్చేందుకు కూడా సుప్రీం నిరాకరణ

సాక్షిలో జగన్ తో పాటు నాక్కూడా సగం వాటా ఉంది: వైఎస్ షర్మిల
సాక్షి పత్రికలో తనపై దుష్ప్రచారం చేస్తున్నారని షర్మిల మండిపాటు
తనను రోజుకొక దొంగతో జగన్ తిట్టిస్తున్నారని ఆగ్రహం
ఏం పీక్కుంటారో పీక్కోండని తీవ్ర వ్యాఖ్యలు

కడప జిల్లా
ఇడుపులపాయ ఎస్టేట్ లో వైఎస్ షర్మిలా రెడ్డి తో వైఎస్ సునీతా రెడ్డి భేటీ
త్వరలో కాంగ్రెస్ పార్టీలో సునీతా రెడ్డి చేరే అవకాశం

నేడు వైఎస్ షర్మిలతో వైఎస్ వివేకా కూతురు సునీత భేటీ..
సునీత పొలిటికల్ ఎంట్రీపై ఊహాగానాలు వెలువడుతున్న వేళ ఇరువురి సమావేశం
షర్మిలతో భేటీలో కీలక నిర్ణయం తీసుకోవచ్చని సమాచారం
ఏపీసీసీగా బాధ్యతలు చేపట్టిన తర్వాత తొలిసారి షర్మిలతో భేటీ కానున్న వైఎస్ వివేకా కుమార్తె
Date: 28/1/2024

మాట నిలబెట్టుకోని మీరు కేడీ కాక మోడీ అవుతారా?: షర్మిల
నేడు తిరుపతి, చిత్తూరు జిల్లాల కాంగ్రెస్ కార్యకర్తల సమావేశం
తిరుపతిలో సమావేశం… హాజరైన షర్మిల
తిరుపతిలో ఇచ్చిన హామీలు ఏమయ్యాయని మోదీని నిలదీసిన వైనం
బాబు, జగన్ కూడా కేడీలేనని విమర్శలు

ప్రపంచంలోనే అత్యంత సంపన్నుడిగా మరోసారి బెర్నార్డ్ అర్నాల్ట్
మళ్లీ నెంబర్ వన్ పీఠాన్ని చేజిక్కించుకున్న బెర్నార్డ్ ఆర్నాల్ట్
ఆర్నాల్ట్ నికర ఆస్తుల విలువ రూ.17 లక్షల కోట్లు
రెండో స్థానానికి పడిపోయిన ఎలాన్ మస్క్

గల్లా జయదేవ్ రాజకీయాలే వద్దని విరమించుకున్నారంటే పరిస్థితి ఎలా ఉందో చూడండి: చంద్రబాబు
నెల్లూరులో రా కదలిరా సభ
హాజరైన టీడీపీ అధినేత చంద్రబాబు
గల్లా జయదేవ్ రాజకీయాల నుంచి తప్పుకోవడాన్ని ప్రస్తావించిన వైనం
ప్రజలే జగన్ కు రిటర్న్ గిఫ్ట్ ఇస్తారని స్పష్టీకరణ
మూడు రెక్కలు విరిచి మొండి ఫ్యాను చేతిలో పెడతారని వ్యాఖ్యలు
Date: 27/01/2024

డ్యాన్సులు తప్ప.. పని చెయ్యవా అంబటీ?: వైఎస్ షర్మిల
గుండ్లకమ్మ ప్రాజెక్టును వైసీపీ ప్రభుత్వం నిర్లక్ష్యం చేస్తోందన్న షర్మిల
ప్రాజెక్టు గేటు నీటిలో తేలుతోందని మండిపాటు
తక్షణమే మరమ్మతు పనులు చేపట్టాలని డిమాండ్
ఇదేనా వైఎస్సార్ ఆశయాలను నిలబెట్టడం?: జగన్ పై మరోసారి మండిపడ్డ షర్మిల
గుండ్లకమ్మ ప్రాజెక్టును పరిశీలించిన షర్మిల
రూ. 750 కోట్లతో వైఎస్సార్ ప్రాజెక్ట్ కడితే.. జగన్ ప్రభుత్వం మెయింటెనెన్స్ కు కోటి కూడా ఇవ్వడం లేదని మండిపాటు
వైఎస్ కట్టిన ప్రాజెక్ట్ మెయింటెన్స్ కూడా చేయని మీరు వారసుడు ఎలా అవుతారని ప్రశ్న
